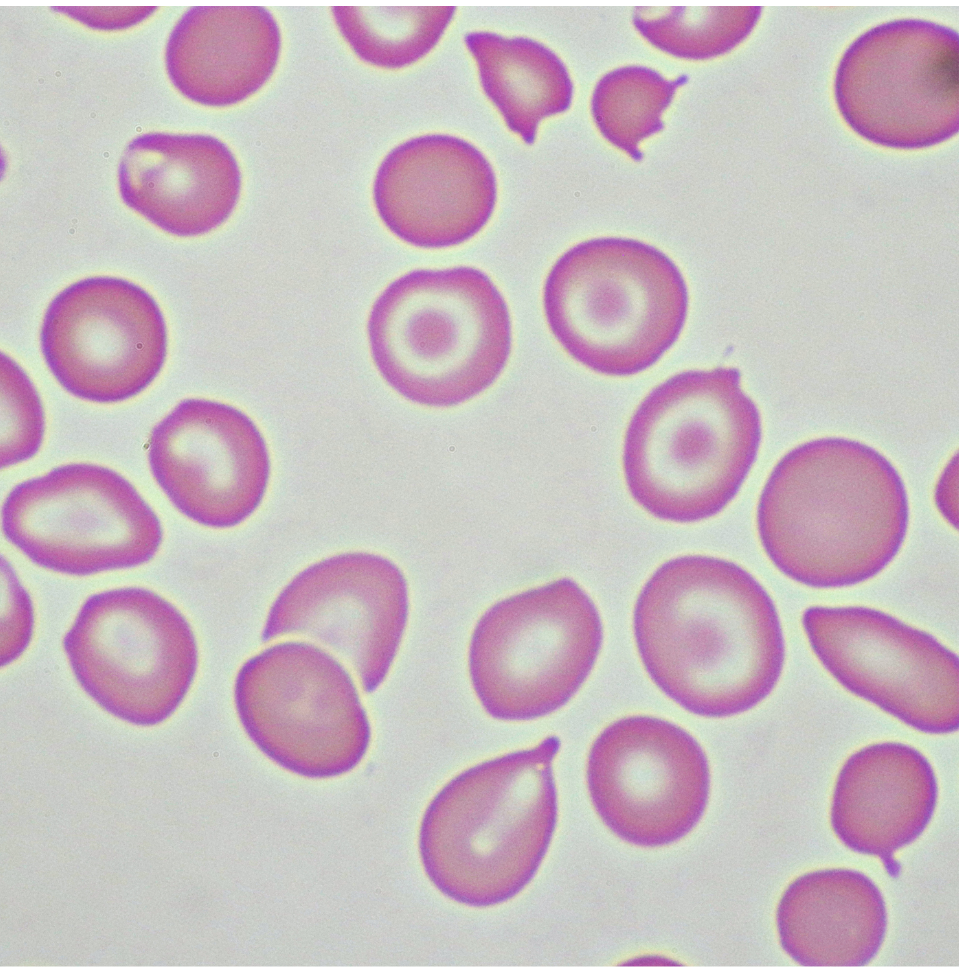
Fructooligosaccharides

key ingredeints

Not all essences are made for sensitive skin

Why It Works
Quick demo, calm skin, easy routine.
Barnabas Oxygen Infuser + Chamomile Essence
A simple two-step ritual for calm, hydrated skin and a healthy glow you can see.
- Deep, long-lasting hydration
- Calms sensitive, easily stressed skin
- Instantly fresher-looking glow
- Ultra-fine mist helps distribute product evenly
- Supports better ingredient uptake
- Designed to feel gentle and comfortable daily
Deep hydration without heaviness
Comfort-first for sensitive skin
Better spread, better finish
Glow now, consistency later
Frequently Asked Questions
Yes! Chamomile Essence is ultra-gentle and perfect for all-day hydration. Use it in the morning to prep, mid-day to refresh, and at night to calm your skin. It can even be used over makeup as a soothing mist.
Just pour a small amount of essence into the infuser tank, mist 6–10 inches from your face, and move in slow circles for 60 seconds. Gently pat in the product after misting, then follow with lotion or cream for best results.
Chamomile Essence is ideal for sensitive, dry, or irritated skin, but gentle enough for all skin types. It's especially great for calming redness, inflammation, or post-acne skin.
Chamomile Essence is more than hydration — it’s healing. It’s packed with soothing ingredients like Chamomile, Lavender, and Sodium Hyaluronate that reduce inflammation and support the skin barrier, with zero harsh chemicals or artificial fragrance.
No — the essence works beautifully on its own. The oxygen infuser simply enhances penetration and turns your skincare into a spa-like ritual.
Use it once or twice daily for best results. You can also mist throughout the day whenever your skin feels tight or stressed.

